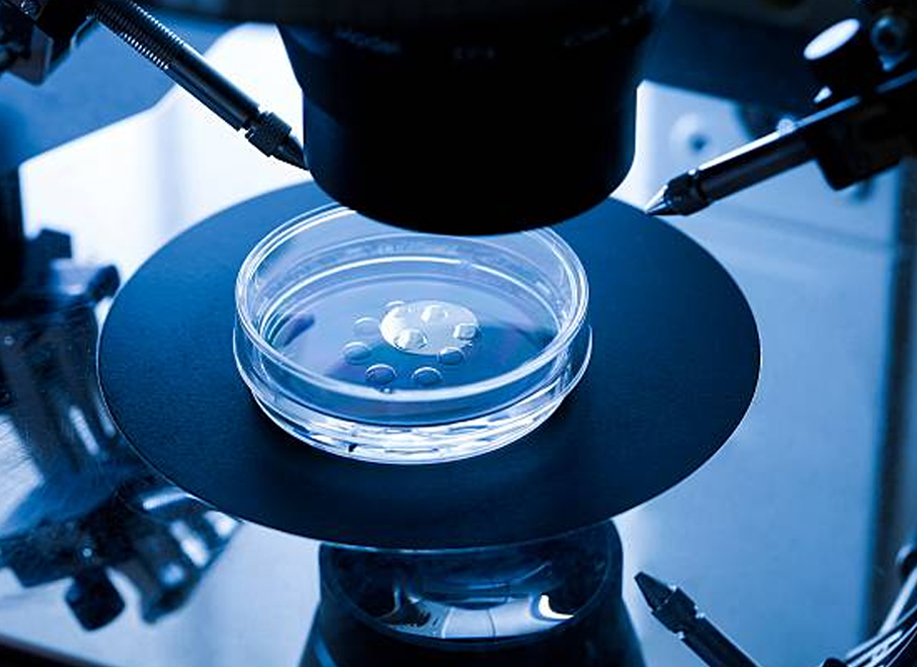

Best fertility clinic in hyderabad
Using advanced procedures like laparoscopy and hysteroscopy, fertility-enhancing surgeries address reproductive challenges with precision and care to improve your chances of conception.
IVF clinic in hyderabad
In Vitro Fertilization (IVF) is a process by which an egg is fertilized by injecting sperm in a laboratory. The embryo formed is then transferred into the uterus where it will hopefully implant and develop further.

Fertility centre Hyderabad
An ideal family has equal number of male and female members, we can help with our Family Balancing Service. Connect with us and works towards a complete family.










